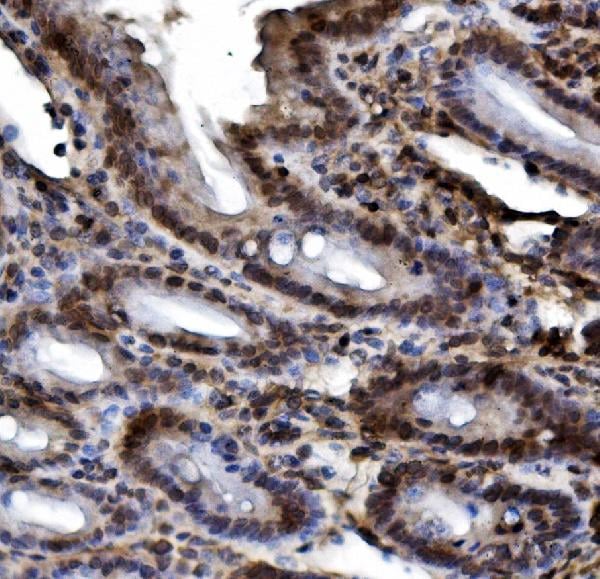

Filters
Clonality
Type
Reactivity
Gene Name
Isotype
Host
Application
Clone
1194 results for " E" - showing 1050-1100
CD163, Monoclonal Antibody (Cat# AAA12256)
Coronin 1a/TACO/CORO1A, Polyclonal Antibody (Cat# AAA19291)
SCG10/STMN2, Polyclonal Antibody (Cat# AAA19299)
Glycine decarboxylase/GLDC, Polyclonal Antibody (Cat# AAA19300)
VDAC3, Polyclonal Antibody (Cat# AAA19301)
CDC45L, Monoclonal Antibody (Cat# AAA19360)
ASS1, Monoclonal Antibody (Cat# AAA19369)
ASS1, Monoclonal Antibody (Cat# AAA19370)
HIF-1 alpha/HIF1A, Polyclonal Antibody (Cat# AAA19213)
MERTK, Polyclonal Antibody (Cat# AAA19219)
ADA, Monoclonal Antibody (Cat# AAA19184)
CD72, Polyclonal Antibody (Cat# AAA19329)
METTL1, Polyclonal Antibody (Cat# AAA19336)
Rad9b, Polyclonal Antibody (Cat# AAA19340)
GRB10, Polyclonal Antibody (Cat# AAA19244)
TBP-1/PSMC3, Polyclonal Antibody (Cat# AAA19314)
GRSF1, Polyclonal Antibody (Cat# AAA19315)
PRMT8, Polyclonal Antibody (Cat# AAA19321)
REA/PHB2, Monoclonal Antibody (Cat# AAA19374)
DDX1, Monoclonal Antibody (Cat# AAA19379)
HSP70, Monoclonal Antibody (Cat# AAA27747)
DR4, Polyclonal Antibody (Cat# AAA10952)
Ran, Polyclonal Antibody (Cat# AAA19131)
No cross reactivity with other proteins.